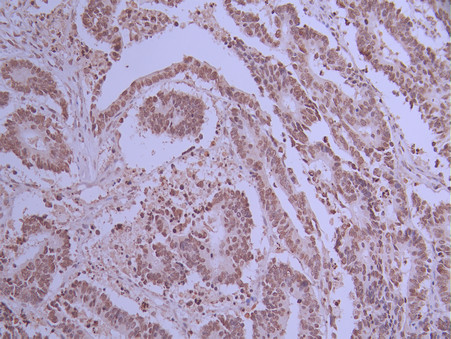

BANF1 Recombinant Monoclonal Antibody
-
中文名稱:BANF1 Recombinant Monoclonal Antibody
-
貨號(hào):CSB-RA098504A0HU
-
規(guī)格:¥1320
-
圖片:
-
IHC image of CSB-RA098504A0HU diluted at 1:100 and staining in paraffin-embedded human colorectal cancer performed on a Leica BondTM system. After dewaxing and hydration, antigen retrieval was mediated by high pressure in a citrate buffer (pH 6.0). Section was blocked with 10% normal goat serum 30min at RT. Then primary antibody (1% BSA) was incubated at 4°C overnight. The primary is detected by a Goat anti-rabbit polymer IgG labeled by HRP and visualized using 0.05% DAB.
-
IHC image of CSB-RA098504A0HU diluted at 1:100 and staining in paraffin-embedded human testis tissue performed on a Leica BondTM system. After dewaxing and hydration, antigen retrieval was mediated by high pressure in a citrate buffer (pH 6.0). Section was blocked with 10% normal goat serum 30min at RT. Then primary antibody (1% BSA) was incubated at 4°C overnight. The primary is detected by a Goat anti-rabbit polymer IgG labeled by HRP and visualized using 0.05% DAB.
-
Overlay Peak curve showing MCF-7 cells stained with CSB-RA098504A0HU (red line) at 1:100. The cells were fixed in 4% formaldehyde and permeated by 0.2% TritonX-100 for 10min. Then 10% normal goat serum to block non-specific protein-protein interactions followed by the antibody (1ug/1*106cells) for 45min at 4℃. The secondary antibody used was FITC-conjugated goat anti-rabbit IgG (H+L) at 1/200 dilution for 35min at 4℃.Control antibody (green line) was Rabbit IgG (1ug/1*106cells) used under the same conditions. Acquisition of >10,000 events was performed.
-
-
其他:
產(chǎn)品詳情
-
Uniprot No.:
-
基因名:BANF1
-
別名:Barrier-to-autointegration factor (Breakpoint cluster region protein 1) [Cleaved into: Barrier-to-autointegration factor, N-terminally processed], BANF1, BAF BCRG1
-
反應(yīng)種屬:Human
-
免疫原:A synthesized peptide from human BANF1 protein
-
免疫原種屬:Homo sapiens (Human)
-
標(biāo)記方式:Non-conjugated
-
克隆類型:Monoclonal
-
抗體亞型:Rabbit IgG
-
純化方式:Affinity-chromatography
-
克隆號(hào):1H11
-
濃度:It differs from different batches. Please contact us to confirm it.
-
保存緩沖液:Preservative: 0.03% Proclin 300
Constituents: 50% Glycerol, 0.01M PBS, PH 7.4 -
產(chǎn)品提供形式:Liquid
-
應(yīng)用范圍:ELISA, IHC, FC
-
推薦稀釋比:
Application Recommended Dilution IHC 1:50-1:200 FC 1:50-1:200 -
Protocols:
-
儲(chǔ)存條件:Upon receipt, store at -20°C or -80°C. Avoid repeated freeze.
-
貨期:Basically, we can dispatch the products out in 1-3 working days after receiving your orders. Delivery time maybe differs from different purchasing way or location, please kindly consult your local distributors for specific delivery time.
-
用途:For Research Use Only. Not for use in diagnostic or therapeutic procedures.
相關(guān)產(chǎn)品
靶點(diǎn)詳情
-
功能:Plays fundamental roles in nuclear assembly, chromatin organization, gene expression and gonad development. May potently compress chromatin structure and be involved in membrane recruitment and chromatin decondensation during nuclear assembly. Contains 2 non-specific dsDNA-binding sites which may promote DNA cross-bridging.; (Microbial infection) Exploited by retroviruses for inhibiting self-destructing autointegration of retroviral DNA, thereby promoting integration of viral DNA into the host chromosome. EMD and BAF are cooperative cofactors of HIV-1 infection. Association of EMD with the viral DNA requires the presence of BAF and viral integrase. The association of viral DNA with chromatin requires the presence of BAF and EMD.; (Microbial infection) In case of poxvirus infection, has an antiviral activity by blocking viral DNA replication.
-
基因功能參考文獻(xiàn):
- BAF and BAF-L might contribute to the shaping of the spermatozoon nucleus and, after fertilisation, its transition to the male pronucleus. PMID: 28684548
- we demonstrate that BAF is necessary to modulate prelamin A effects on chromatin structure PMID: 26701887
- Findings support the value of using BioID to identify unrecognized constituents of distinct subcellular compartments refractory to biochemical isolation and reveal VRK2A as a transmembrane kinase in the NE that regulates BAF. PMID: 28637768
- It has been concluded that the LEM domain, responsible for binding to the chromatin protein BAF, undergoes a conformational change during self-assembly of emerin N-terminal region. PMID: 27960036
- antiviral capabilities of the barrier to autointegration factor (BAF/BANF1) and how its function and regulation places BAF at the junction of multiple pathways protecting a cell's genetic integrity PMID: 26842478
- The findings unveil a unique mechanism where the nuclear periphery proteins lamin-A/C, LAP2alpha and BAF1 are assembled into a protein complex during mitosis in order to regulate assembly and positioning of the mitotic spindle. PMID: 26092935
- results demonstrate a novel function of BAF as an epigenetic regulator of HSV lytic infection; hypothesize that BAF facilitates Herpes Simplex Virus IE and E gene expression by recruiting the SETD1A methyltransferase to viral IE and E gene promoters PMID: 26015494
- Vaccinia virus B1 kinase is needed for multiple critical junctures in the poxviral life cycle in a manner that is both dependent on and independent of BAF. PMID: 26223647
- BAF is a cytosolic DNA sensor that leads to exogenous DNA avoiding autophagy. PMID: 25991860
- These data suggest that VRK3-mediated phosphorylation of BAF may facilitate DNA replication or gene expression by facilitating the dissociation of nuclear envelope proteins and chromatin during interphase. PMID: 25899223
- Association of emerin with nuclear BAF in cells required the LEM domain (residues 1-47). PMID: 25052089
- The BANF1, alanine 12 threonine (A12T) mutant is impaired in its ability to bind DNA while its interaction with nuclear envelope proteins is unperturbed. PMID: 25495845
- Altogether, these data demonstrate that phosphoregulation of BAF by viral and cellular enzymes modulates this protein at multiple molecular levels, thus determining its effectiveness as an antiviral factor and likely other functions as well. PMID: 24600006
- Data indicate that the major phosphatase responsible for dephosphorylation of of BAF Ser-4 to be protein phosphatase 4 catalytic subunit. PMID: 24265311
- Activation of BANF1 possibly suppresses S100A9 expression and inactivates c-Jun, resulting in suppression of cutaneous inflammation PMID: 23664529
- Emerin and BAF associated only in histone- and lamin-B-containing fractions. The S173D mutation specifically and selectively reduced GFP-emerin association with BAF by 58% PMID: 24014020
- The decrease in vaccinia virus transcription caused by loss of B1 kinase can be rescued by depletion of BAF. PMID: 23891157
- The accumulation of wild-type prelamin A detected in restrictive dermopathy as well as the accumulation of mutated forms identified in familial partial lipodystrophy and mandibuloacral dysplasia affect the nuclear localization of BAF protein. PMID: 22935701
- BAF associated in vivo with SET/I2PP2A (protein phosphatase 2A inhibitor; blocks H3 dephosphorylation) and G9a (H3-K9 methyltransferase), but showed no detectable association with HDAC1 or HATs. PMID: 22127260
- A single copy of normal BANF1 is sufficient to avoid the development of Nestor-Guillermo progeria syndrome. PMID: 21932319
- The absence of direct binding of BAF to MAN1-C eliminates disruption of this interaction as the cause of the premature aging phenotype. PMID: 21966431
- Data determined that the knockdown of Banf1 alters the cell cycle distribution of both human and mouse ESCs by causing an uncharacteristic increase in the proportion of cells in the G2-M phase of the cell cycle. PMID: 21750191
- The authors demonstrate that the DNA binding and dimerization capabilities of BAF are essential for its function as an antipoxviral effector, while the presence of emerin is not required. PMID: 21880762
- These nuclear abnormalities are rescued by ectopic expression of wild-type BANF1, providing evidence for the causal role of this mutation. PMID: 21549337
- Cooperation of ATP-dependent remodeling, histone methylation, and kinase activation, followed by H1 displacement, is a prerequisite for the subsequent displacement of histone H2A/H2B catalyzed by PCAF and BAF. PMID: 21447625
- These findings are supported by coimmunoprecipitation of prelamin A or progerin with BAF in vivo and suggest that BAF could mediate prelamin A-induced chromatin effects. PMID: 20581439
- BAF and emerin have dynamic roles in genome integrity and might help couple DNA damage responses to the nuclear lamina network PMID: 19759913
- The barrier-to-autointegration factor (BAF)-binding domain of emerin is located at the emerin N-terminus (residues 70-178) and includes the LEM-domain. PMID: 11792821
- BAF is required for the assembly of emerin and A-type lamins at the reforming nuclear envelope during telophase and may mediate their stability in the subsequent interphase. PMID: 11792822
- BAF may have a role in regulating emerin-GCL repressor complexes PMID: 12493765
- report that BAF protein is a component of preintegration complexes isolated from HIV-1-infected cells PMID: 12663813
- HB and barrier-to-autointegration factor are the same protein PMID: 14523012
- BAF protein was detected in activated but not resting CD4+ T-lymphocytes. BAF bound directly to both p55 Gag and its cleaved product, matrix. PMID: 14645565
- Data describe the mobility of barrier-to-autointegration factor to its partners emerin, LAP2 beta, and MAN1 in the nuclear membrane of living HeLa cells. PMID: 15109603
- LAP2alpha and BAF transiently localize to telomeres and specific regions on chromatin during nuclear assembly PMID: 15546916
- BAF bridges DNA using two pairs of helix-hairpin-helix motifs located on opposite surfaces of the BAF dimer without changing its conformation. PMID: 16155580
- phosphorylation at Ser175 regulates the dissociation of emerin from BAF PMID: 16204256
- Ser-4 phosphorylation inhibits BAF binding to emerin and lamin A, and thereby weakens emerin-lamin interactions during both mitosis and interphase. PMID: 16371512
- These results indicate that barrier-to-autointegration factor is required for the integrity of the nuclear lamina and normal progression of S phase in human cells. PMID: 17519288
- We now show that BAF acts as a potent inhibitor of poxvirus replication unless its DNA-binding activity is blocked by B1-mediated phosphorylation. PMID: 18005698
- analyses in human cells showed that barrier-to-autointegration factor (BAF), assembled first at the distinct ;core' region of the telophase chromosome and formed an immobile complex by binding with NE proteins, such as lamin A and emerin. PMID: 18628300
顯示更多
收起更多
-
相關(guān)疾病:Nestor-Guillermo progeria syndrome (NGPS)
-
亞細(xì)胞定位:[Barrier-to-autointegration factor]: Nucleus. Cytoplasm. Chromosome. Nucleus envelope.
-
蛋白家族:BAF family
-
組織特異性:Widely expressed. Expressed in colon, brain, heart, kidney, liver, lung, ovary, pancreas, placenta, prostate, skeletal muscle, small intestine, spleen and testis. Not detected in thymus and peripheral blood leukocytes.
-
數(shù)據(jù)庫鏈接:
Most popular with customers
-
-
YWHAB Recombinant Monoclonal Antibody
Applications: ELISA, WB, IHC, IF, FC
Species Reactivity: Human, Mouse, Rat
-
Phospho-YAP1 (S127) Recombinant Monoclonal Antibody
Applications: ELISA, WB, IHC
Species Reactivity: Human
-
-
-
-
-